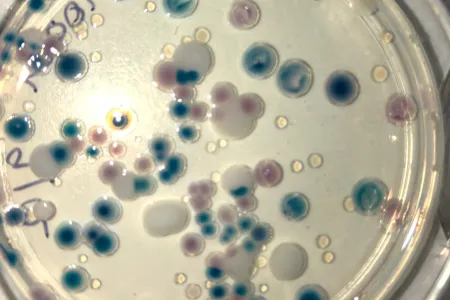
top down view of circular culture plate, with a variety of sizes of scattered blobs: black, white, brown, and clear

Our research focus
We conduct high impact research and customized research consultancies that focus on detecting and interpreting microbiological threats in a complex world. We specialise in microbiological and molecular analyses in aquatic and terrestrial environments, including animal-microbe interactions, and analyses of sediment, water and biota. Our research supports shellfish food safety, safe drinking water and animal health, and we use microbial signatures to monitor the footprint of pollution in the environment.
Research topics
- Microbial DNA detection & diagnosis
- Emerging pathogens
- Opportunistic pathogens in water
- Microbial source tracking
- Monitoring impact
About us
Anna PadovanI have worked in molecular microbiology for 30 years, with the last 15 years in the area of environmental microbiology. My work captures the microbiology of wastewater to assess effective treatment, the molecular detection of toxic cyanobacteria, understanding changes in the microbiome of shellfish in relation to anthropogenic impacts, and the detection and enumeration of pathogens using molecular tools in marine snails and oysters. Of particular interest is understanding the Vibrio bacteria community in the tropical marine waters and oysters in relation to seasons and climate, with emphasis on the human and animal pathogenic strains. |
Deborah HoltI am a molecular biologist with a research interest in the molecular epidemiology and molecular pathogenesis of organisms including Sarcoptes scabiei, Staphylococcus aureus, Streptococcus pyogenes, Chlamydia trachomatis, and Strongyloides stercoralis, including antimicrobial resistance detection and mechanisms. I also have a particular interest in the analysis of microorganism genome sequence data, particularly as it can be applied in the development of molecular tools that can be used as rapid and cost-effective techniques for the surveillance of any organism of interest. This has synergies with the work of other BNA team members. My passion is laboratory work and helping to foster students at all levels. |
Karen GibbI am an environmental microbiologist with expertise in aquatic and marine systems and the impact of environmental change and industrial pollution on water quality and marine harvest, especially oysters. I am also interested in developing ways to monitor the health of marine systems and led a team that in 2021 produced the first Darwin Harbour Integrated Report Card. My scientific output includes 160 refereed papers, over 5,000 citations and an h-index of 40 but the most rewarding aspect of my job is being part of the incredibly dedicated and professional BNA team, mentoring postgraduate students and collaborations with researchers from other universities, NT Government and First Nation Scientists. |
Mirjam KaestliI am a molecular microbiologist and biostatistician with expertise in opportunistic pathogens such as the melioidosis agent Burkholderia pseudomallei. I have co-authored more than 80 refereed papers and co-edited and co-written a book chapter on the occurrence of B. pseudomallei in the environment. My current research focus is the microbial water quality of drinking water including biofilm formation in the water supply and the dynamics of microbial communities from groundwater through the distribution system. Using bacterial genome sequence data, I also have experience in microbial source tracking and examining the relatedness of bacterial isolates e.g. from outbreaks, over time or across locations. |
Zarah TinningI am a Research Assistant and PhD candidate within the BNA team, specialising in environmental molecular microbiology. During my time at BNA, I have contributed to research in areas such as aquatic faecal pollution, algal toxins and Vibrios within marine organisms and their environments. |
Our values
Our research group operates under a multiple leadership model that encourages independence and embraces innovation. We are solution oriented, positive and supportive both within the team and in our interactions with partners.
In our research and research consultancy interactions we aim to provide customised research solutions. We aim to be flexible, responsive, versatile and adaptable in all our interactions.
Project examples – both past and present
- Safety of Aquatic Foods in relation to effluent discharge.
- Detection of cyanotoxins in wastewater targeting genes in synthesis pathways.
- Molecular detection/enumeration of faecal indicators.
- Detection of soil-transmitted helminths in wastewater from remote communities.
- The occurrence of opportunistic pathogens in drinking water.
- Microbial source tracking in freshwater springs and pools, in drinking water and sewers.
- Drinking water, bore water and water tank microbiome analysis including iron cycling bacteria.
- Biofilm formation in drinking water distribution systems.
- Bacterial communities in anaerobic digestors.
- Bacterial corrosion.
- Frog-toad and reptile skin microbiome dynamics over space and time.
- Fish skin and gut microbiome dynamics in relation to parasite load.
- Migratory shorebird gut microbiome (Vibrios) in relation to migration and season.
- Microbes in the nesting mounds of orange-footed scrub-fowl.
Snapshot of collaborative research with Industry
Oyster aquaculture
Aquaculture can provide strong and sustainable employment opportunities for remote communities in the NT. The Tropical Rock Oyster Development (TROD) project was first established to help meet demand in First Nations communities for oyster aquaculture systems, and has already led to positive business opportunities.
RIEL researchers joined the collaborative project to help investigate low-technology sea-based aquaculture systems and particularly to sample Blacklip Rock Oysters from 10 locations across the NT. The team assessed shellfish quality, including testing for Vibrio bacteria which occurs naturally in warm waters, with the aim of supporting food safety and quality control in the emerging Blacklip Rock Oyster industry in the region.
The results of this research support the livelihoods of First Nations peoples in northern Australia. As part of the work, researchers also undertook outreach activities, such as a workshop in Warruwi, South Goulburn Island, on Vibrio research relating to oyster production in the area.
Biosecurity
Moving forward, we are now involved in a project Managing climate-change driven pathogen biosecurity threats in the north. This is an Indigenous-led marine water quality surveillance program that tackles the increasing risks to human and animal health from climate-change driven pathogen biosecurity threats. This program is drawing on traditional knowledge about sea changes and linking these to pathogen biosecurity threats.
Selected publications and reports
Publications
- Weitzman C, Tinning Z, Day K, Garnett S, Christian K and Gibb K (2024). Migratory shorebird gut microbes are not associated with bivalve prey in monsoon tropical Australia. Current Microbiology, 81:111 https://doi.org/10.1007/s00284-024-03628-6
- Fortune, J., van de Kamp, J., Holmes, B., Bodrossy, L., Gibb, K. and Kaestli, M (2024). Dynamics of nitrogen genes in intertidal sediments of Darwin Harbour and their connection to N-biogeochemistry. Marine Environmental Research, 198: 106500. https://doi.org/10.1016/j.marenvres.2024.106500
- Fortune, J., Butler, E. C., & Gibb, K. (2023). Estuarine benthic habitats provide an important ecosystem service regulating the nitrogen cycle. Marine Environmental Research, 106121. https://doi.org/10.1016/j.marenvres.2023.106121
- Anna Padovan , Karen Kennedy , Karen Gibb (2023) A Microcystin Synthesis mcyE/ndaF Gene Assay Enables Early Detection of Microcystin Production in a Tropical Wastewater Pond. Harmful Algae. https://doi.org/10.1016/j.hal.2023.102476
- Padovan, A.C.; Turnbull, A.R.; Nowland, S.J.; Osborne, M.W.J.; Kaestli, M.; Seymour, J.R.; Gibb, K.S. Growth of V. parahaemolyticus in Tropical Blacklip Rock Oysters. Pathogens 2023, 12, 834. https://doi.org/10.3390/pathogens12060834
- C Weitzman, M Kaestli, A Rose, CM Hudson, K Gibb, GP Brown, R Shine and KA Christian (2023). Geographic variation in bacterial assemblages on cane toad skin is influenced more by local environments than by evolved changes in host traits. Biology Open (2023) 12, https://doi.org/10.1242/bio.059641
- Davis J, Garcia EA, Gibb KS, Kennard MJ, Rose A, Stromsoe N and Wedd D (2023), The importance of groundwater for riverine fish faunas in a region of shale gas development in northern Australia. Frontiers in Environmental Science 11:1106862. https://doi.org/10.3389/fenvs.2023.1106862
- BJ Currie, EM Meumann, M Kaestli. (2023) The Expanding Global Footprint of Burkholderia pseudomallei and Melioidosis. The American Journal of Tropical Medicine and Hygiene 108(6):1081-1083. https://doi.org/10.4269/ajtmh.23-0223
- Gomez, K. C., Rose, A., Gibb, K. S., & Christian, K. A. (2022). Microbial communities associated with mounds of the Orange-footed scrubfowl Megapodius reinwardt. PeerJ, 10, e13600. https://doi.org/10.7717/peerj.13600
- J Fortune, M. Kaestli. E Bulter, K Gibb (2022). Denitrification in intertidal sediments of a tropical estuary subject to increasing development pressures. Aquatic Sciences 84, 53. https://doi.org/10.1007/s00027-022-00885-0
- Patrick Munk,Christian Brinch,Frederik Duus Møller,Thomas N. Petersen, Rene S. Hendriksen, Anne Mette Seyfarth, Jette S. Kjeldgaard, Christina Aaby Svendsen, Bram van Bunnik, Fanny Berglund, Global Sewage Surveillance Consortium, Artan Bego, Pablo Power, Catherine Rees, Dionisia Lambrinidis, Elizabeth Heather Jakobsen Neilson, Karen Gibb, Kris Coventry, Peter Collignon, Susan Cassar (2022) Genomic analysis of sewage from 101 countries reveals global landscape of antimicrobial resistance. Nature Communications. 67032211. https://doi.org/10.1038/s41467-022-34312-7
- A Padovan, N Siboni, M Kaestli, WL King, JR Seymour, K Gibb (2021) Occurrence and dynamics of potentially pathogenic vibrios in the wet-dry tropics of northern Australia. Marine Environmental Research 169, 105405. https://doi.org/10.1016/j.marenvres.2021.105405
- A Rose, A Padovan, K Christian, J van de Kamp, M Kaestli, S Tsoukalis, K Gibb (2021) The Diversity of Nitrogen-Cycling Microbial Genes in a Waste Stabilization Pond Reveals Changes over Space and Time that Is Uncoupled to Changing Nitrogen Chemistry Microbial ecology 81 (4), 1029-1041. https://doi.org/10.1007/s00248-020-01639-x
- K Christian, R Shine, KA Day, M Kaestli, K Gibb, CM Shilton, GP Brown (2021) First line of defence: Skin microbiota may protect anurans from infective larval lungworms. International Journal for Parasitology: Parasites and Wildlife 14, 185-189. https://doi.org/10.1016/j.ijppaw.2021.02.014
- WL King, M Kaestli, N Siboni, A Padovan, K Christian, D Mills, J Seymour, K. Gibb (2021) Pearl oyster bacterial community structure is governed by location and tissue-type, but Vibrio species are shared among oyster tissues. Frontiers in Microbiology 12, 723649. https://doi.org/10.3389/fmicb.2021.723649
- BJ Currie, M Mayo, LM Ward, M Kaestli, EM Meumann, …, NM Anstey (2021) The Darwin Prospective Melioidosis Study: a 30-year prospective, observational investigation. Lancet infectious diseases 21(12),1737-46. https://doi.org/10.1016/S1473-3099(21)00022-0
- EM Meumann, M Kaestli, M Mayo, L Ward, A Rachlin, …, BJ Currie (2021) Emergence of Burkholderia pseudomallei sequence type 562, northern Australia. Emerging Infectious Diseases 27(4), 1057. https://doi.org/10.3201/eid2704.202716
- J Fortune, ECV Butler, K Gibb (2020) A decade of nitrogen inputs to a tropical macrotidal estuary of Northern Australia, Darwin Harbour. Regional Studies in Marine Science 36, 1012752. https://doi.org/10.1016/j.rsma.2020.101275
- HM Luter, CD Kenkel, M Terzin, T Peirce, PW Laffy, K Gibb, NS Webster (2020) Gene correlation networks reveal the transcriptomic response to elevated nitrogen in a photosynthetic sponge. Molecular Ecology 29 (8), 1452-1462. https://doi.org/10.1111/mec.15417
- A Padovan, K Kennedy, D Rose, K Gibb (2020) Microbial quality of wild shellfish in a tropical estuary subject to treated effluent discharge. Environmental Research 181, 108921. https://doi.org/10.1016/j.envres.2019.108921
- A Rachlin, M Mayo, JR Webb, M Kleinecke, V Rigas, …, M Kaestli (2020) Whole-genome sequencing of Burkholderia pseudomallei from an urban melioidosis hot spot reveals a fine-scale population structure and localised spatial clustering in the environment. Scientific Reports 10, 5443. https://doi.org/10.1038/s41598-020-62300-8
- M Kaestli, N Munksgaard, K Gibb, J Davis (2019) Microbial diversity and distribution differ between water column and biofilm assemblages in arid-land waterbodies Freshwater Science 38 (4), 869-882. https://doi.org/10.1086/706106
- K Day, H Campbell, A Fisher, K Gibb, B Hill, A Rose, SN Jarman (2019) Development and validation of an environmental DNA test for the endangered Gouldian finch. Endangered Species Research 40, 171-182. https://doi.org/10.3354/esr00987
- A Rose, A Padovan, K Christian, M Kaestli, K McGuinness, S Tsoukalis, K. Gibb (2019 New Pond—Indicator Bacteria to Complement Routine Monitoring in a Wet/Dry Tropical Wastewater Stabilization System. Water 11 (11), 2422. https://doi.org/10.3390/w11112422
- C Duvert, CR Priadi, AM Rose, A Abdillah, DR Marthanty, KS Gibb, M Kaestli (2019) Sources and drivers of contamination along an urban tropical river (Ciliwung, Indonesia): Insights from microbial DNA, isotopes and water chemistry. Science of the Total Environment 682, 382-393. https://doi.org/10.1016/j.scitotenv.2019.05.189
- M Kaestli, M O’Donnell, A Rose, JR Webb, M Mayo, BJ Currie, K Gibb (2019) Opportunistic pathogens and large microbial diversity detected in source-to-distribution drinking water of three remote communities in Northern Australia. PLoS neglected tropical diseases 13 (9), e0007672. https://doi.org/10.1371/journal.pntd.0007672
- CL Weitzman, M Kaestli, K Gibb, GP Brown, R Shine, K Christian (2019) Disease exposure and antifungal bacteria on skin of invasive cane toads, Australia. Emerging infectious diseases 25 (9), 1770. https://doi.org/10.3201/eid2509.190386
- A Rose, N Munksgaard, M Kaestli, L Bodrossy, J Van de Kamp, K. Gibb (2019) Wastewater nitrogen budgets can be resolved by complementary functional gene and physicochemical methods. Journal of Water Process Engineering 29, 100802. https://doi.org/10.1016/j.jwpe.2019.100802
- NC Munksgaard, LB Hutley, KN Metcalfe, AC Padovan, C Palmer, K. Gibb (2019) Environmental challenges in a near-pristine mangrove estuary facing rapid urban and industrial development: Darwin Harbour, Northern Australia. Regional Studies in Marine Science 25, 100438. https://doi.org/10.1016/j.rsma.2018.11.001
- CL Weitzman, K Gibb, K Christian (2018) Skin bacterial diversity is higher on lizards than sympatric frogs in tropical Australia. PeerJ 6, e5960. http://doi.org/10.7717/peerj.5960
- K Christian, C Weitzman, A Rose, M Kaestli, K Gibb (2018) Ecological patterns in the skin microbiota of frogs from tropical Australia. Ecology and Evolution 8 (21), 10510-10519. http://doi.org/10.1002/ece3.4518
- S Mumtaz, C Streten, DL Parry, KA McGuinness, P Lu, KS Gibb (2018) Soil uranium concentration at ranger uranium mine land application areas drives changes in the bacterial community. Journal of Environmental Radioactivity 189, 14-23. https://doi.org/10.1016/j.jenvrad.2018.03.003
- SA Stephenson, TM Nelson, C Streten, KS Gibb, D Williams, P Greenfield, A. Chariton (2018) Sea-level rise in northern Australia’s Kakadu National Park: a survey of floodplain eukaryotes. Marine and Freshwater Research 69 (7), 1134-1145. https://doi.org/10.1071/MF18067
- SP Guenther, KS Gibb, AM Rose, M Kaestli, KA Christian (2018) Differences in structure of northern Australian hypolithic communities according to location, rock type, and gross morphology. AIMS microbiology 4 (3), 469. https://doi.org/10.3934/microbiol.2018.3.469
- NC Munksgaard, S Burchert, M Kaestli, SJ Nowland, W O'Connor, (2017) Cadmium uptake and zinc-cadmium antagonism in Australian tropical rock oysters: Potential solutions for oyster aquaculture enterprises. Marine Pollution Bulletin 123 (1-2), 47-56. http://dx.doi.org/10.1016/j.marpolbul.2017.09.031
- K Christian, M Kaestli, K Gibb (2017) Spatial patterns of hypolithic cyanobacterial diversity in Northern Australia. Ecology and evolution 7 (17), 7023-7033. https://doi.org/10.1002/ece3.3248
- M Kaestli, A Skillington, K Kennedy, M Majid, D Williams, K McGuinness, K. Gibb (2017) Spatial and temporal microbial patterns in a tropical macrotidal estuary subject to urbanization. Frontiers in microbiology 8, 1313. https://doi.org/10.3389/fmicb.2017.01313
- MA Trenfield, JW van Dam, AJ Harford, D Parry, C Streten, K Gibb, R Van Dam (2017) Assessing the chronic toxicity of copper and aluminium to the tropical sea anemone Exaiptasia pallida. Ecotoxicology and environmental safety 139, 408-415. http://dx.doi.org/10.1016/j.ecoenv.2017.02.007
- KN Warnakulasooriya, ECV Butler, KS Gibb, NC Munksgaard (2017) Stable isotopes in biota reflect the graduated influence of sewage effluent along a tropical macro-tidal creek. Marine and Freshwater Research 68 (10), 1855-1866. https://doi.org/10.1071/MF16080
- AC Padovan, MJ Neave, NC Munksgaard, KS Gibb (2017) Multiple approaches to assess the safety of artisanal marine food in a tropical estuary. Environmental monitoring and assessment 189 (3), 1-15. https://doi.org/10.1007/s10661-017-5842-5
- K Gibb, X Schobben, K Christian (2017) Frogs host faecal bacteria typically associated with humans. Canadian journal of microbiology 63 (7), 633-637. http://dx.doi.org/10.1139/cjm-2017-0119
- NC Munksgaard, KN Warnakulasooriya, K Kennedy, L Powell, KS Gibb (2017) Enrichment of 15N/14N in wastewater-derived effluent varies with operational performance of treatment systems: implications for isotope monitoring in receiving environments, Environmental monitoring and assessment 189 (1), 1-10. https://doi.org/10.1007/s10661-016-5754-9
Reports
- Measuring ecosystem function in Darwin Harbour sediment using microbial nitrogen cycling genes (PDF, 3.66 MB)
- Developing quantitative PCR assays to target microbial nitrogen cycle genes: A new tool to monitor ecosystem function in sediment (PDF, 2.91 MB)
- Microbial Source Tracking at Berry Springs Pools (PDF, 4.88 MB)
Please make contact if you would like to work with us
Bioscience North Australia (BNA)
Charles Darwin University
Ellengowan Drive, Brinkin, NT 0909